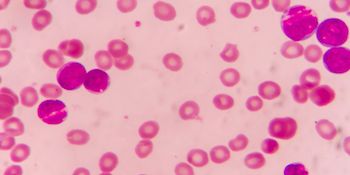

Hematology
Latest News

Latest Videos

CME Content
More News

Policy
Updates from the annual ASH meeting, December 2018.

Published results confirm the efficacy of tisagenlecleucel in patients with relapsed or refractory diffuse large B-cell lymphoma.

Maintenance therapy with lenalidomide remains a standard of care for patients with multiple myeloma. However, optimizing maintenance therapy in this setting is required as a result of lenalidomide’s lack of overall survival benefit and improvement in outcomes for patients with high-risk cytogenic abnormalities, according to a recent study.

Bristol-Meyers Squibb (BMS) and Celgene kicked off the 37th Annual JP Morgan Healthcare Conference by discussing their leading drugs, near-term launches, and early pipeline assets.

As a physician, Brian Koffman, MDCM, DCFP, DABFM, MS Ed, medical director, CLL Society, was able to leverage his medical and scientific knowledge during treatment for his chronic lymphocytic leukemia (CLL), and he encourages other patients to educate themselves on their illnesses in order to receive the best care.

Pediatric patients with early-stage Hodgkin lymphoma who are treated with chemotherapy followed by radiotherapy, known as combined modality therapy, have an improved 5-year survival rate compared with patients treated with chemotherapy alone.

Elizabeth Griffiths, MD, associate professor of oncology, department of medicine, Roswell Park Comprehensive Cancer Center discusses recent approvals for acute myeloid leukemia (AML).

Children with Hodgkin lymphoma who are treated during childhood and survive to adulthood have higher incidence rates of breast, lung, colorectal, and thyroid cancer than the general population, according to a recent study.

Patients who are over 60 with Hodgkin lymphoma have much lower survival rates than patients who are under 60, explained Alison J. Moskowitz, MD, medical oncologist, clinical director, lymphoma inpatient unit, Memorial Sloan Kettering Cancer Center.

Patients who are treated with chemotherapy for their solid tumors have an increased risk of therapy-related myelodysplastic syndrome and acute myeloid leukemia (tMDS/AML) despite advances in chemotherapy regimens, according to a new study in JAMA Oncology.

There have been incredible responses to treatments for chronic lymphocytic leukemia (CLL), but there remains a tremendous unmet need for patients, said Brian Koffman, MDCM, DCFP, DABFM, MS Ed, medical director, CLL Society.

Throughout the year, The American Journal of Managed Care® (AJMC®) offered a number of video programs, including Peer Exchange discussions and interviews, on a range of topics. Here are the most-watched videos published by AJMC® in 2018.

During the 60th American Society of Hematology Annual Meeting & Exposition held December 1-4 in San Diego, California, Norman Sharpless, MD, director, National Cancer Institute (NCI), brought attention to several advances made in hematologic malignancies over the past year and highlighted 4 areas of focus going forward.

Ibrutinib-containing regimens have similar overall survival rates but significantly higher progression-free survival (PFS) rates at 2 years compared with bendamustine plus rituximab.
Following failure with ruxolitinib, there are limited treatment options available and among these patients who fail on the treatment, prognosis is unfavorable, particularly among those who started ruxolitinib with advanced stage disease, according to a study presented at the 60th American Society of Hematology Annual Meeting & Exposition.

ELOQUENT-3 trial results found that adding elotuzumab to pomalidomide and dexamethasone improved progression-free survival (PFS) and overall response rate in patients with multiple myeloma that had relapsed from or were refractory to (R/R) lenalidomide and a proteasome inhibitor.

According to a study presented at the 60th American Society of Hematology Annual Meeting & Exposition, held December 1-4 in San Diego, California, a World Health Organization–defined diagnosis of primary myelofibrosis may help better identify patients who may need strict monitoring during treatment with ruxolitinib.

Once-daily gilteritinib pills have been approved to treat adult patients with relapsed or refractory acute myeloid leukemia (AML) with a FLT3 mutation. Approximately 25% to 30% of patients with AML have this mutation, which is associated with an aggressive form of the disease and carries a higher risk of relapse.

In patients who relapse after allogeneic hematopoietic stem-cell transplantation, the therapeutic benefits that transplantation provide is diminished through mechanisms that remain unclear. A new study analyzed the genetic and epigenetic alterations of leukemic cells to determine any common features of relapse after transplantation

FDA has recently approved 2 new treatments for patients age 75 and older who are newly diagnosed with AML and have other chronic health conditions or diseases that may mean they cannot use intensive chemotherapy.

From December 1-4, hematology professionals from across the globe will convene in San Diego, California for the American Society of Hematology annual meeting to present and discuss their research and latest developments in malignant and non-malignant hematology. Here’s what to look out for during the meeting.

AMT-061, an AAV5 vector containing factor IX (FIX)-Padua variant, has been shown to increase FIX activity to threshold FIX levels sufficient to significantly reduce the risk of bleeding events without the risk of adverse immune reactions.

A new investigational drug has demonstrated high response rates in patients with a rare but highly aggressive blood disease that currently has no approved therapies, according to new research led by investigators at The University of Texas MD Anderson Cancer Center.

Since chimeric antigen receptor (CAR) T-cell therapy is still in early development there are benefits and risks that eligible patients will have to weigh, including the durable response against the limited amount of data and toxic side effects, said Brian Koffman, MDCM, DCFP, DABFM, MS Ed, medical director, CLL Society.

The FDA announced Friday it expanded the approved use of brentuximab vedotin (Adcetris) in combination with chemotherapy for adult patients with certain types of peripheral T-cell lymphoma, using a new review process designed to increase efficiency.